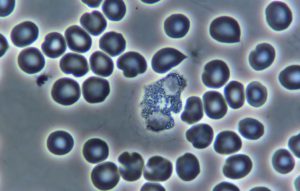
Phase Contrast

Next LIVE Workshop: October 2-5, 2025. See Events Page for details.

Unleash the Power of the Picture
Live Cell Microscopes for Extraordinary Imaging
Live Blood Analysis*
Live Cell Qualitative Auditing
Dry Layer Blood Clot Retraction Viewing
Microorganism Seek & Search
Dental/Gingival Scanning
Pleomorphic Studies
Liposomal Research
Motility Studies
Education
Industry
*This term as used here is for search engine purpose, our microscope systems are for educational use only within the biological science and industrial arts arenas, and not for medical diagnostic use.

Proudly representing Olympus systems to our health education market niche since 1996.
From our first microscope workshop in Phoenix Arizona in March of 1996 through current all-encompassing classes at our Biotorium Health Learning Lab in Chicago, we have been leading the charge for health care practitioners who want to engage their client base in new ways.
With Biomedx HD video microscopy, your clients can be taken on a fantastic voyage through their "life in the blood." This provides them an unprecedented education on what makes their health tick, while at the same time giving them a driving motivation to act on healthy lifestyle protocols.
In 1999 we developed one of the most highly regarded state of the art multi-platform microscopes for alternative and complimentary health practitioners to help them offer one of a kind client health education. We kept up that level of excellence over the ensuing years with version updates. Today we have a new system for another generation.
For busy practitioners it is smooth, very fast to operate, and provides incredible micro imaging. For docs and staff alike, it is almost impossible to screw things up. (And with over 20 years of providing tech support to practitioners and staff we know all the ways that can happen.) With our next gen model and its engineered integrations, it all makes for a trouble-free and consistently accurate microscope experience.

The Biomedx enhanced and configured Olympus multi-platform microscope for the next generation of the Wellness Revolution.

It's Where the Image Conveys the Message
Absolutely Beautiful on the Desktop
Step through the slides here to see the imaging versatility:
And Excellent For BIG Screen Presentations.

Superb Microscope Optics Deserve Superior Display

Industrial Vision Cameras for Biological Science Education
For our select health education market we tested numerous camera chip sets, formats, interfaces and operability factors to get it right. For microscope presentation modes, we found straight USB only cameras didn’t cut it. Being limited to video image viewing through a computer interface had many inherent problems. However, HDMI output through a standard HDTV – with the right camera chipset – makes for a beautiful experience.
For those that want to manipulate images on a computer via software, this camera can be completely software driven with an optional WIFI connection (software and WIFI connector included with all systems). The camera however can do it all on-board as needed.
A wired mouse connects directly to the camera so no computer hookup is even necessary if you’d rather not move to that level of complication. You can capture images and video directly to the removable memory card in the camera, zoom in and out of your image, even manipulate your auto or manual control settings to adjust your video imaging on the fly.
One thing we discovered in testing numerous cameras for our systems is that camera specifications do not tell the whole story.
We’ve seen great specs that we thought would be stellar performers, but when all hooked up they did not have the live cell imaging we demanded and many failed at providing good darkfield light sensitivity.
Far more important than a raw megapixel count is pixel physical size and the relationship of pixel quantity to standard HDTV dimensions for the best on-screen view which is what we want.
Many cameras might look the same on the outside, but the tech inside can be a different story. Our cameras incorporate ultra high performance Sony sensor technology for video microscopy with super-size pixels for huge dark signal sensitivity.
On our scopes with these cameras you get good live blood darkfield imaging using only the multi-mode turret condenser – even without having to use oil. And that is awesome when things get busy or you have staff doing your educational presentations – it means no oily mess or continual cleanup.
Video Overviews
See the Range of This Systems Versatility...

The Multi-mode Universal Condenser in Action...

Zooming Flexibility...

Yesterday's Monitors vs. the HDTV of Today...

Microscope System Pricing
Most Popular
$6250
- Exactly what you need. This is our core microscope system that is shown in the videos above that do it all in an easy and most efficient manner. 2x, 4x, 10x, 20 & 40x phase objectives – all non-oil – gets you cleanly up and going with the best available technology. Includes our incredible camera and optical components to give you an overall biological viewing and educational super tool that has the capability of serving you for decades. Perfect for dry layer, live cell, gingival, urine, sperm, soil, water, white blood cell counting and more.
- *Price shown reflects package discount, payment by check or bank transfer. $6430 via credit/debit card.
100x Oil
$6980
- This is our complete 'Most Popular' system where we take out the 4x objective and plug in a 100x oil phase objective for increased resolution and magnification for the times you might want that. It likely won’t be the day to day optic for most clinics, but when you want that close up detail view of an organism for deeper research or image and video publishing - or are having those big screen live blood wine and cheese parties - this system will give you imaging with all the Olympus oil optic phase contrast brilliance. (See video below to check it out.)
- *Price shown reflects package discount, payment by check or bank transfer. $7180 via credit/debit card.
Everything
$8890
- This is the same system as the 100x oil unit, but includes a 50x oil iris objective for a bit of darkfield refinement. It is set up to go out the door with the 2x, 20x, 40x, 50x and 100x objectives in place, and includes the 4x and 10x objectives on the side for the times you may want to install those for viewing specific media. As you might be swapping objective positions at times, this system includes the phase centering telescope to be used if and when needed.
- *Price shown reflects package discount, payment by check or bank transfer. $9150 via credit/debit card.
While adding oil objectives are not really necessary for most day to day viewing of live blood, gingival work or more, for some the added magnification and bump in resolution is something they want.
Note that the oil objective options can be added at any time to a system in the future if desired.
The video here that was posted on YouTube will show you the use of a 100x oil phase objective and the imaging you can expect to see on a TV monitor.

Our core system can be configured to operate as your low cost nano scanner which the video here highlights.
This was was another YouTube installment that shows a brief review of a liposomal product with our core microscope system that showed a surprising result.
We left in the part that shows the simple technique for getting a liposomal sample but with a grid block to hide the tested product brand name.

All of our systems come standard with:
The Biomedx MicroImagePro Camera and related imaging software which you can use or not as desired since the camera has internal software as well. The camera plugs directly into any HDTV and is ready to go without any required computer. (HDTVs give the best imaging performance and most provide an abundance of additional picture controls to tweak your live view image even further.)
A Quick Setup Guide showing you how to put it all together along with the Olympus microscope manual itself.
This is a System for Health Education 2nd to None
This is the perfect system for the health care facility engaged in education and helping people understand the deeper details of their health.
In the misnomered "live blood analysis" health market niche, it was often said that you need to have a "darkfield" microscope in order to see what you want in blood. Well, that is very old information based on literature written prior to the invention of phase contrast microscopy by Frits Zernicke.
Phase contrast provides shading and morphological discernment for many blood elements that is simply unattainable in darkfield mode, although darkfield does have its place and is used where appropriate. But it is not the mode for viewing living blood that some might have you believe.
Today some teachers that sell microscopes in their programs still put out the old information about requiring darkfield along with oil as well. Often this position is held because the microscopes they have just don't do phase contrast very well and they have to use oil with their systems to get the performance they want.
With the systems here that's not the case. You get total performance excellence all around for your live blood journeys with your clients.
Market Realities of Cheap Systems
One reality we have had to deal with is microscope sellers promising their systems to do “darkfield” or "live blood" imaging with scopes that are somewhat cheap. Problem is, darkfield imaging and especially phase contrast are not done very well by so many companies. Phase contrast itself is a mode that requires perfection that many cannot provide, but Olympus does.
There is also a certain “feel” to operating some of these off and other brand microscopes that simply put, is kind of clunky. They often need continual adjustment and when they are adjusted, do not offer consistent operation or image quality. By comparison, our configured Olympus systems operate smooth as silk and are continually consistent in operation.
We have had many come to a workshop that have previously purchased lower tier microscope systems get quickly spoiled when they work with ours where they then proceed to purchase one and have a need to sell what they previously bought. You don't need to find yourself in that situation.
We are here for you!
We service a professional health care market and put our name behind this as well. We don’t just sell microscopes, we also support the health care practitioner and others doing this work.
Our perspective is that if you are a pro, you should want the best microscope at the best price without compromise and where the best imaging and quality is concerned, you can’t beat Olympus and the Biomedx configuration and video setup for these systems. If best is what you want with a company that has served this market for over two decades and offers concurrent support as well as dynamic training should you want it, well you’ve found us.
Frequently Asked Questions
Yes. We have a great lease company in Wisconsin that can do this and some in Canada. If you have an existing lease company we can work with them. Outside of the North American market we do not have lease resources.
Note that a lease company typically wants to see a track record of being in business at least 2 years with a good credit history. Getting a lease on a new business or start up is difficult.
If you are in the difficult category and still want to make timed payments, we do take credit cards and there are a few credit card companies out there that extend zero percent financing for the first 6 to 12 months on a new card. You can do a search for one of those companies if that situation fits.
Yes, always. If you purchased any system and decided you wanted to add another objective for example, you can do that at any time. Systems are totally flexible in that way.
No, the multi-mode universal condenser on the Olympus CX43 is factory set in place and cannot be removed.
On the plus side, this makes any technical screw ups that might happen with adjustment and calibration of the condenser almost non-existent.
No. As per the last question the multi-mode turret condenser is fixed to the frame and no other condenser can be used.
The only darkfield condenser we imagine you might want would be a dedicated oil cardioid darkfield condenser. These are the best for pure darkfield applications and we used these sometimes in our older system for individuals that wanted it, but those weren’t many.
The references in some writings that certain blood forms can best be seen or only appear in darkfield were written before the invention of phase contrast.
Phase contrast changed the game yet today some still adhere to those old references. Part of this is because there are a lot of poor phase contrast objectives in the marketplace with poor imaging. If that is all one has available, then using an oil cardioid darkfield condenser with a LOT of light to push through it would likely be much better.
That said, Olympus makes incredible phase contrast objectives. With image rendition to an HD monitor and having a full range of shading capability form white to black and everything in-between, live blood imaging and more is simply stellar with phase contrast.
For many with this new technology, darkfield has become passe.
However with a multi-mode condenser and our darkfield enhancer on the CX43, you can have both, super phase contrast and pretty decent darkfield as well. This might be for times you’ll flip to it to check out nuclei in white blood cells or for white cell counting, or for additional differentiation of those or other forms as you might desire.
For a primary display that is economical and looks great, consider a standard flat panel HDTV with 23″ being the smallest. (You can also travel with these pretty easily if you are a roving microscopist.) We have a few 23″ models made by Vizio on desktop arm mounts in our workshop space on the microscope benches and they look great. With an HDTV the image can also be optimally tweaked from the TV menu while straight computer monitors don’t always offer the same level of image adjustment as a TV does.
28″ can also work very well with a desktop arm mount while also providing a larger image for a bit more impression.
Our cameras put out a 1920×1080 size image and that is what you will find in smaller monitors. These are also known as 1080P. Smaller monitors could also be 720P but you will want one that does 1080P not the 720.
If you’re going for very impressive presentations, consider a 40-50″ or so wall mount TV.
The larger HDTVs today are all moving to 4K today which is double 1920×1080. Ideally a 4K camera would be desired for this but currently we have yet to test one that was satisfactory for our purpose. As we mentioned elsewhere on this webpage, specs are not everything and a lot goes into getting the right image we need and want to see out of a camera.
That said, the 4K TVs today do a decent job of upscaling standard HDTV to their 4k mode. So you could get a 4K now and when a suitable camera is available you could update your system at that time if desired. However the image as it is now is outstanding and you may not feel the need to be upgrading anything for a long time.
Standard big screen HDTVs are getting really inexpensive so cost-wise they are a great deal and the basic 1080P display exactly matches the camera and the imaging is the best when you have camera and monitor matched. Either way, having HDTV as a main display (as opposed to a computer monitor) for your system is the way to go for most.
Our cameras also output WIFI if desired for a secondary display to see the image on a laptop or tablet using the included imaging software. If you are traveling with your scope to do a distance presentation away from the main office, you could use a laptop monitor as your main screen in a pinch, but it is not the best as there is a slight WIFI lag in passing the real time image from the scope to the camera. But as we previously noted, a 23″ HDTV for example is very light and travels very easy as well while also providing a superb image.
Yes absolutely, this is new equipment. The warranty is in the tab section below.
And here is something to know: In two decades of selling Olympus microscopes, we’ve never had a single warranty issue arise, ever. Olympus microscopes are engineered and built very well.
The only repair issues that seem to arise are typically travel related – TSA, baggage handlers, etc, – or something like a client smashing a cable when closing their suitcase.
With this system you can rest assured that if you keep it clean and put a dust cover on it before bed, you will have a solid microscope and component group that will work for you every day like the first for a very long time.